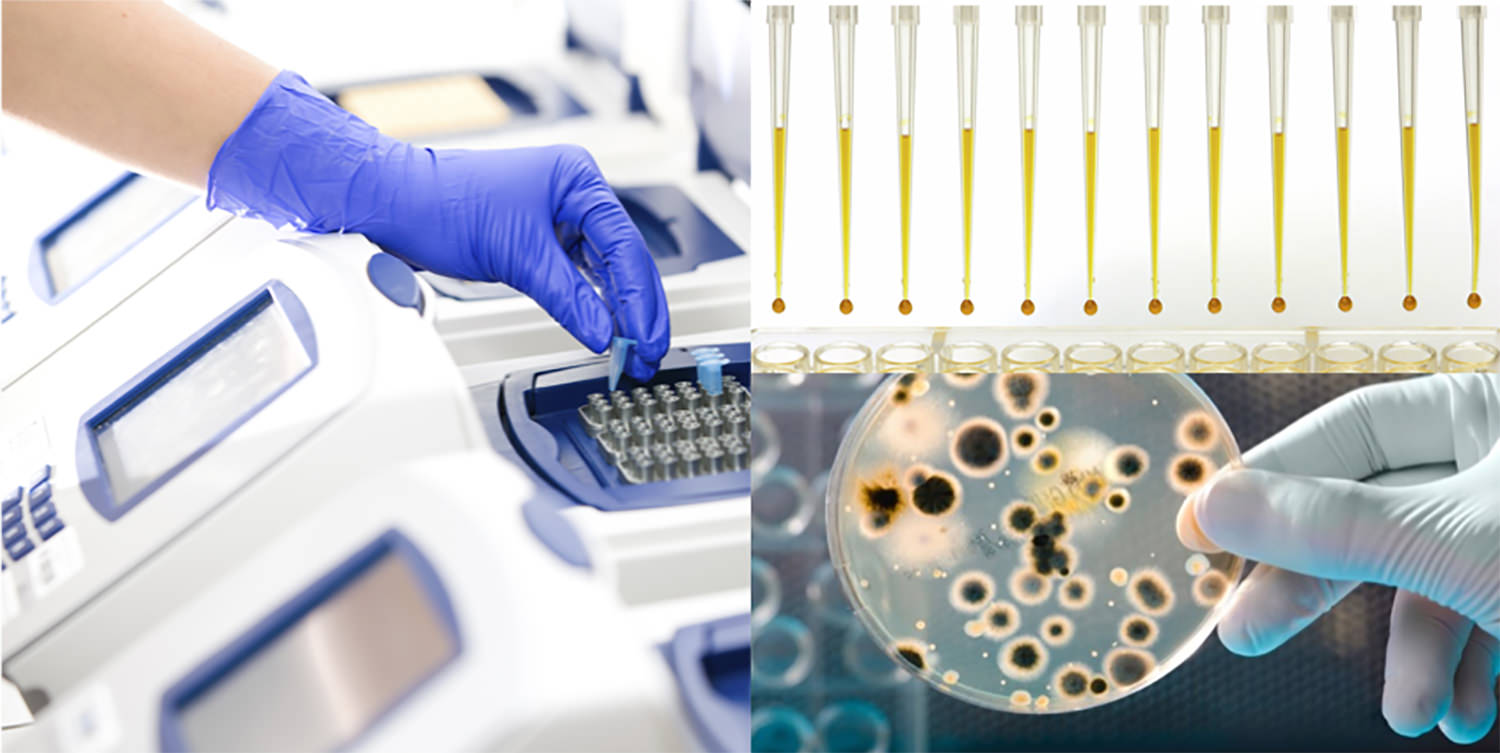
sqr

votre partenaire pour les problématiques combustibles et carburants
Nous concevons, développons et fabriquons des solutions adaptées pour traiter l’ensemble des inconvénients rencontrés depuis le stockage des hydrocarbures jusqu’aux rejets des gaz après combustion.
NOS SOLUTIONS DE TRAITEMENT SONT À LA POINTE DE LA TECHNOLOGIE ET SONT DÉVELOPPÉES POUR L’ENSEMBLE DE NOS PARTENAIRES ET CLIENTS
Applications
DISTRIBUTEUR DE CARBURANTS ET COMBUSTIBLES
Nos solutions pour vous permettre de proposer des carburants et combustibles améliorés, différenciants et à forte valeur ajoutée pour vos clients
Applications
TRANSPORT ROUTIER / BTP
Nos solutions pour traiter l’ensemble des inconvénients rencontrés depuis le stockage des hydrocarbures jusqu’aux rejets des gaz après combustion
Applications
Transport Maritime & Fluvial
Nos solutions pour traiter l’ensemble des inconvénients rencontrés depuis le stockage des hydrocarbures jusqu’aux rejets des gaz après combustion
Applications
PROFESSIONNELS DE LA ROUTE
Nos solutions pour l’entretien préventif et curatif des organes moteurs de votre véhicule.
NOS PRODUITS ET SERVICES
Notre gamme couvre l’ensemble des problématiques des carburants et combustibles rencontrées par les distributeurs et les utilisateurs, depuis le stockage jusqu’à la combustion.
En plus de notre gamme existante, nous pouvons également proposer des formulations sur-mesure pour les besoins spécifiques de nos clients.
Nos produits pour le traitement
Gazole et BioDiesels




Nos produits pour le traitement
Fioul Domestique et GNR


Notre produit pour le
traitement Essence

Nos produits de spécialités


NOTRE OFFRE DE SERVICE
Mexel en chiffres
1990
DEPUIS
8
BREVETS MONDIAUX
7
certifications environnementales
95%
clients récurrents
EXPERIENCE ET EXPERTISE
MEXEL Industries est une société française fondée en 1990, avec des installations industrielles situées à Verberie, à 60 km au nord de Paris.
MEXEL Industries s’appuie sur un comité scientifique pour la conception de ces produits. Les technologies développées par MEXEL sont couvertes par des brevets mondiaux.
Notre division Mexel Hydrocarbures conçoit, développe et fabrique, depuis plus de 10 ans, des solutions adaptées et spécifiques pour traiter l’ensemble des inconvénients rencontrés depuis le stockage des hydrocarbures jusqu’aux rejets des gaz après combustion.
Notre expérience et notre expertise font de notre société le partenaire idéal pour résoudre vos problématiques des carburants et combustibles.
ENVIRONNEMENT ET
DEVELOPPEMENT DURABLE
Fortement portée sur le développement durable, la société a notamment été pionnière dans la certification de ces produits, en étant l’un des premiers acteurs français à faire tester dès 2011 son traitement MexDiesel GO par le groupe UTAC CERAM selon le cycle de conduite 60 NERV protocolé ADEME.
Depuis 2012, les produits de traitements des carburants développés par Mexel Industries sont éligibles à la charte « OBJECTIF CO2 » .
La société a aussi été moteur du secteur pour l’obtention des certificats d’économies d'énergie, en portant la fiche C2E TRA-EQ-119 « Optimisation de la combustion et de la propreté des moteurs Diesel » auprès de l’ATEE.
CERTIFICATIONS

La société est certifiée ISO 9001
(version 2015)

L’efficacité et la performance environnementale des solutions MEXEL ont été mesurées par l’UTAC CERAM et validées par l’ADEME (protocole NERV60).
+ Décrassage du moteur et systèmes de dépollution (EGR).
- 4,4% des émissions de CO2.
- 14,4% des rejets de d'oxydes d’azote.

Depuis 2012, les produits de traitements des carburants développés par Mexel Industries sont éligibles à la charte « OBJECTIF CO2 »
Les carburants additivées avec les solutions Mexel respectent les normes en vigueur: EN 590 pour le gazole, EN 228 pour l’essence, EN 14214 pour le B30.

Les produits Biocide proposés par Mexel Industries sont enregistrés sur la base SIMMBAD de l’ANSES.
La stratégie d’innovation de Mexel Industries, en termes de création de produits, procédés ou techniques, a été récompensée à plusieurs reprises :

OSEO Excellence
Trophée de l’innovation FF3C
Lauréat Deloitte Nord Picardie
Trophée du développement durable
NOS PARTENAIRES
Mexel Industries est soutenue dans son développement
par différents partenaires